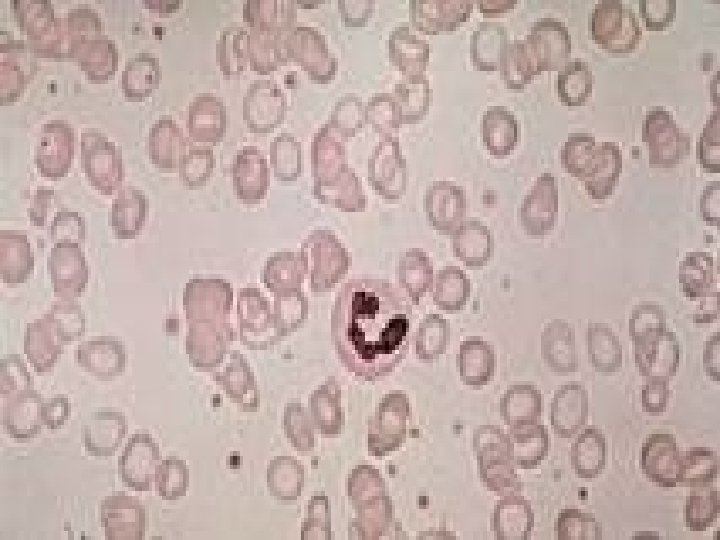

ANAEMIA IN PREGNANCY PHYSIOLOGICAL CHANGES DURING PREGNANCY Plasma

- Slides: 40
ANAEMIA IN PREGNANCY � ������ �
PHYSIOLOGICAL CHANGES DURING PREGNANCY: Plasma volume increase by 50% Red cell mass increase by up to 25% There is consequent fall in Hb concentration, Haematocrit and red cell count because of haemodilution , start from 6 -8 weeks , this is maximum at 32 weeks of gestation.
-Mean cell volume increase 2 nd to erythropoiesis -Mean cell Hb concentration remains stable -Serum iron and ferritin concentrations decrease 2 nd to increase utilization
Total iron binding capacity increase Iron requirement increase (due to expanding red cell mass and fetal requirement ) from 2. 5 mg/day in the first trimester to 7. 5 mg /day in the third trimester. There is moderate increase in iron absorption
-Folate requirements increase in pregnancy up to 400 microgram per day(due to fetus, placenta, uterus and expanding maternal red cell mass. ) -Body store of B 12 around 3 mg and daily requirement around 3 micro gram pr day, so pregnancy has no major effect on B 12 stores.
Definition of anemia: WHO recommends that the Hb concentration should not fall below 11 g/dl during 1 st and 2 nd trimster and 10. 5 g/dl during 3 rd trimester of pregnancy INCIDENCE Around 30 -50%of women become anemic during pregnancy , 90%iron deficiency 5% folate , always under lying cause (malabsorption , dietery, increased use in Hb pathy ). B 12 rare
IRON DEFECIENCY ANAEMIA Is hypochromic microcytic anemia , is commonest cause of anemia in pregnancy. increase iron requirement in pregnancy met by increase utilization of iron store and increase iron absorption. If the store is depleted the anemia developed rapidly in pregnant.
Clinical features: Symptoms -May be no symptoms especially mild anemia -In moderate anaemia patient may complain of : feeling of weakness, exhaustion, lassitude, indigestion, loss of appetite, palpitation , dyspnea, edema and rarely anasarca, even congestive cardiac failure in severe cases Signs: -No sign in mild anemia -Pallor glossitis, stomatitis -Edema due to hypoproteinemia , soft systolic murmer at mitral area, fine crepitation at base of lung due to congestion
Diagnosis: -Decrease in Hb concentration is the most practical methods. -MCV<80 FL , MCH <27 pg and MCHC all are low in IDA , but not accurate in pregnancy. -ferrtin level<12 micrigram/l indicate the IDA, serum ferrtin not affected by pregnancy
-SI decrease below 60 microgram/l (normal range 60 -120) -TIBC increased >350 (normal range 300500 microgram) -Transferrin saturation decrease <15% (Calculated from SI and serum ferrtin) -Peripheral blood film hypochromic microcytic anemia ansiocytosis , poikilocytosis, target cell
The effect of iron deficiency anemia in pregnancy: Maternal effect: -Mild anemia may have no effect and become moderate to severe anemia in subsequent pregnancy -Moderate anemia : increase weakness , easy fatigability , poor performance tiredness , lethargy pallor,
-Severe anemia associated with poor out come: -Palpitation, breathlessness , increase cardiac out put , cardiac stress decompensation , cardiac failure may be fatal , - PTL - PE - sepsis post partum tissue healing may be compromised -blood loss at delivery may be tolerated poorly in anemic patient. Fetal effect: Anemia associated with adverse perinatal out come- PTL , - Hb below 6 g/dl (severe anemia) associated with SGA, IUGR, PMR increase-
TREATMENT oral iron effective if there is enough time. increase in Hbo. 8 g/dl per week the recommended dose is 120 -240 mg of elemental iron per day. ferrous salts better absorb than ferric salt, vitamin C taken simultaneously aids absorption so take iron with fresh orange juice
Side effect: -10% of of patients develop side effect , gastrointestinal , malabsorption , blood loss -The side effect can ameliorated if the dose decrease to 100 mg per day or change preperation. Patient cannot tolerated iron tablet can use enteric coated tablet or liquid suspension -Theraputic result can be expected after 3 weeks of therapy.
Parenteral therapy: has no advantage over the oral iron if is well tolerated The main advantage of parenteral therapy is the certainty of its administration to correct the Hb deficit and to build up the iron store the rise in Hb by 1 gram/week as oral. -adequate treatment should result in a marked increase in the reticulocyte count with in 7 -14 days
intramascular iron ; sorbitol citrate(Jectofer) (by deep IM injection rapidly absorb S. E pain at side of injection, tattooing decrease by. Ztype of injection, abscess reaction , N and V, headache, fever, lymphadenopathy rarely anaphylaxsis.
Dextran(imferon) I. V , I. M risk of anaphylactic reaction Iron sucrose new I. V preparation with few side effect.
BLOOD TRANSFUSION: Indication: 1 -Toward the end of pregnancy, severe anemia after 36 week of pregnancy 2 -when rapid increase in the Hb concentration is needed to replenish the blood loss due to antipartum and post partum hemorrhage 3 - in patients not responding to oral or parenteral iron therapy Packed cell are preferred to transfusion Risk: Anaphylactic reaction. Precipitate PTLOver loading of the heart-
MACROYTIC ANAEMIA -Folate deficiency is less common. - suggested by an increased MCV , WBC with altered morphology hypersegmented nutrophilis , poikilocytosis, ansiocytosis. appear after 7 weeks of deficiency.
-folate requirement are increase in pregnancy so all tissues requirement are increase in pregnancy. folate level decrease due to haemodilution and folate. -supplementation 0. 4 mg per day has been shown to reduce the incidence of neural tube defects.
5 mg additional dose required in women receiving anti convulsant medication and in high risk patient for NTD giving preconceptional and during 1 st trimester.
Diagnosis Folate level in fasting state <3 mg/ml B 12 <80 pg/ml indicate deficiency Treatment 0. 5 -1 mg folate orally daily B 12 1 mg I M weekly until anemia resolves. retic count increase with in 3 -7 days.
Effect on pregnancy; Increased incidence of abortion IUGR PE Abruptio placetae Effect on fetus Increased incidence of NTD Prematurity SGA
HAEMOLYTIC ANAEMIA SICKLE CELL SYNDROMES Autosomal inherited disease abnormal Hb. S contains beta –globin chains with amino acid substitution that results in it precipitating when in its reduce state. the red blood cell become sickle shaped and occlude small blood vessels (sickling)
SICKLE-CELL DISEASE Sickle cell disease (Hb. SS) is severe condition and pregnant women are at high risk of complications. pregnancy associated with an increased incidence of sickle cell crises that may result in episodes of severe pain, typically affecting the bones or chest.
Crises precipitated by hypoxia, stress, infection and hemorrhage. women are at increase risk of miscarriage , pre-eclampsia, chest and urinary tract infections; premature labor , growth restriction.
ANTENATAL MANAGEMENT 1 -All women should be screened at booking to detect haemoglobinopathies, if heterozygote for a haemoglobinopathy , her partner should also tested. 2 -Prenatal test for couples at risk of having an affected baby 3 -Prevention of sickling : no specific treatment , hypoxia, dehydration, infection should be avoided by aggressive treatment with adequate analgesia antibiotic oxygen and rehydration
4 -Hb concentration of at least 10 g/dl with 6 o% normal Hb. A will minimize the risk of crises. blood transfusion , exchange transfusion may be used to increased Hb A its role in pregnancy is controversial. 5 -vaginal delivery should be the aim and epidural anaesthesia advised to reduce the stress of labor , avoid dehydration, cooling, infection , hypoxia during labor, continuous fetal monitoring is recommended. Postnatal period still at risk of sickling. 6 -Contraception: Both combined and progesterone only pills can use
THALASSEMIA -Is the commonest genetic blood disorders the defect is reduced production of normal hemoglobin -Either alpha or beta types: In alpha type there is a deletion of one of two normal genes required for Hb production the affected individual is chronically anemic , screen of the women partner for thalassemia and consider prenatal diagnosis
if both affected so chance 1; 4 of having affected fetus with alpha thalassemia major In alpha thalassaemia major , there is no functional alpha chain , no normal Hb is synthesized and the condition is incompatible with life , the fetus develops marked hydrops and pregnancy complicated by polyhydramnios , preterm labor , preeclampsia.
Treatment: no treatment but antenatal diagnosis in subsequent pregnancy.
The beta thalassaemia result from defects in the normal production of beta chains. normal Hb contains mostly Hb. A 1 , with a small percentage of Hb. A 2. If gene for production Hb. A 1 is missing the individual has beta thalassaemia minor All pregnant women should screen by electrophoresis
Beta thalassaemia minor-trait is not a problem antenatal , all tend to be mildly anaemic, low MCV, iron and folate should be given and partners should be screen 1: 4 chance of having fetus with no gene for production of Hb A 1(bthalassaemia major) if both thalassaemia minor.
the fetus produces Hb. F in utero and this is not a problem, in post natal life normal Hb. A 1 can not produced and severe anaemia developes need frequent blood transfusion lead to over load an death.
THANK YOU